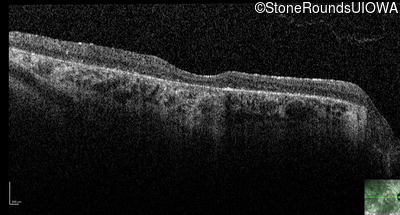
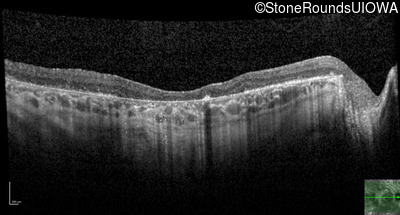
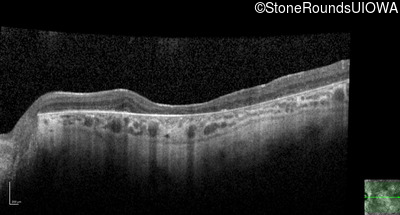
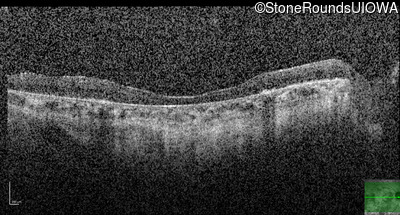
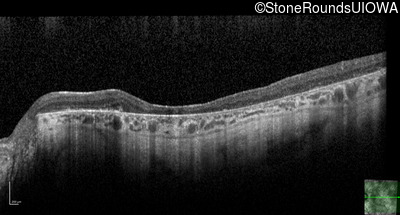
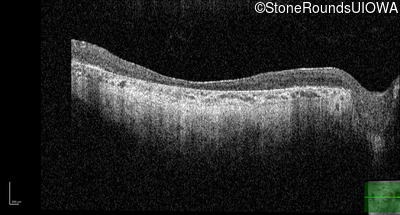
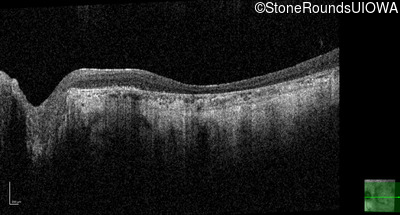
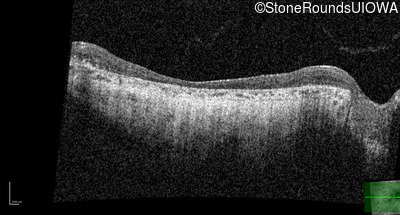

Case
SR1008
Student Mode
Usher Syndrome (IB1)
Female
Female
Hidden
SR1008
Student Mode
Usher Syndrome (IB1)
Female
Female
History
This 38 year old woman had normal vision until age 22 when she noticed poor night vision when working as a camp counselor after college. Her hearing loss was first noticed at age 3 and was correctable with hearing aids.
| Age at visit: 38 years |
| Age at visit: 38 years (Visit 2) |
| Age at visit: 39 years |
| Age at visit: 41 years |
| Age at visit: 42 years |
| OD | OS | ||
|---|---|---|---|
| OD | OS | ||
|---|---|---|---|
Diagnosis & molecular findings
| Disease | Gene | Allele 1 variant(s) | Allele 2 variant(s) | Inheritance mode |
|---|---|---|---|---|
| Usher Syndrome | TUBB4B | Arg262Gln CGG>CAG | AD |